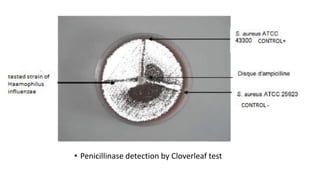
• Penicillinase detection by Cloverleaf test
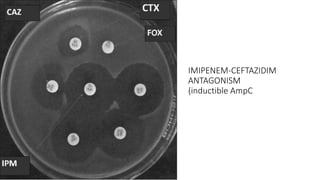
IMIPENEM-CEFTAZIDIM
ANTAGONISM
(inductible AmpC
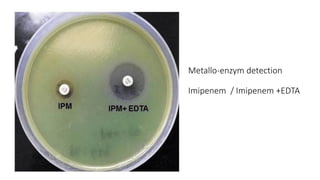
Metallo-enzym detection
Imipenem / Imipenem +EDTA

The document provides an overview of β-lactam antibiotics and β-lactamases, highlighting their structures, classifications, and detection methods. It emphasizes the rise of β-lactamase-producing bacteria as a significant public health concern due to their role in antibiotic resistance. The document concludes with a call for simplified classification systems and the importance of continued research on these enzymes in the context of antimicrobial resistance.